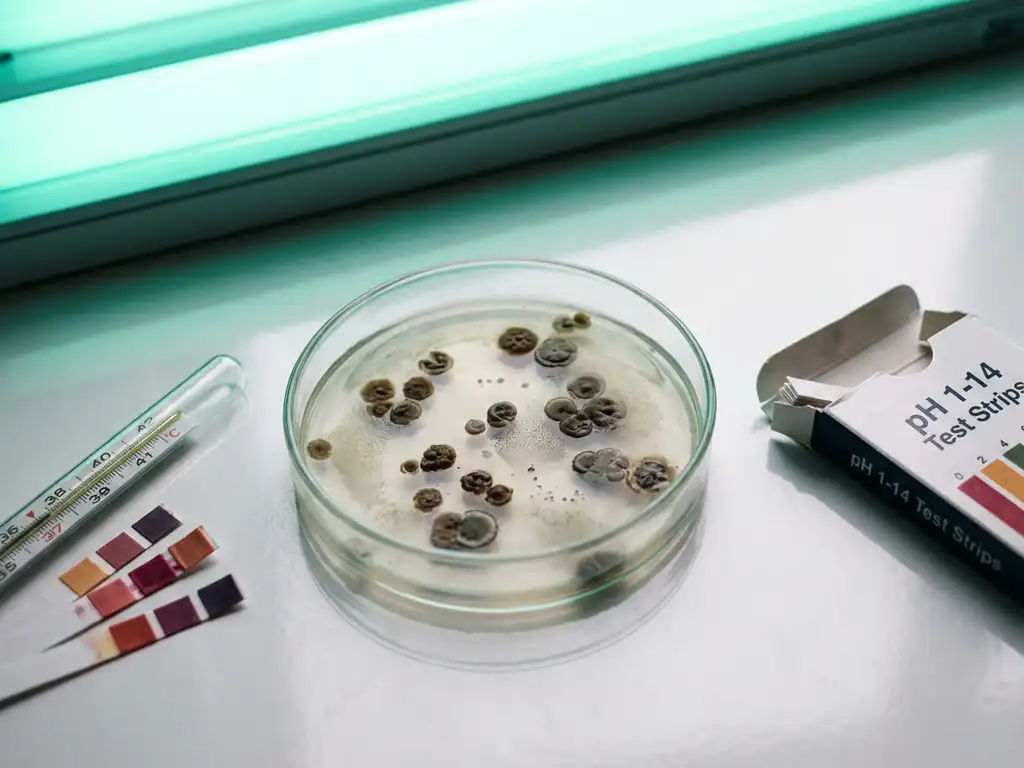
Failed probiotic bacteria cultures in laboratory petri dish with thermometer and pH strips on sterile countertop

Probiotic products fail in clinical trials due to inadequate preclinical validation, poor strain selection, dosage optimisation issues, and significant inter-individual variability. The disconnect between promising laboratory results and real-world effectiveness stems from oversimplified testing conditions that do not replicate the harsh, dynamic environment of the human gut. Understanding these failure modes and implementing better preclinical testing approaches can dramatically improve clinical success rates.
What are the main reasons probiotic products fail in clinical trials?
Probiotic clinical trials fail primarily due to inadequate preclinical validation, poor strain selection, dosage optimisation problems, and a failure to account for inter-individual variability. These failure modes create what researchers call the “Valley of Death” between promising laboratory results and disappointing clinical outcomes.
The fundamental disconnect occurs because standard laboratory conditions bear little resemblance to the human gut environment. Laboratory settings use sterile Petri dishes with optimal pH levels and abundant nutrients, whereas the human gut presents a harsh, dynamic environment in which probiotics must survive stomach acid (pH 1.5–2.0), bile salts, digestive enzymes, and intense competition from trillions of established gut bacteria.
Poor strain selection compounds these challenges. Many probiotic products enter clinical trials without sufficient mechanistic evidence of how specific strains interact with the human gut microbiome. Dosage optimisation represents another critical failure point, as researchers often rely on arbitrary dosing rather than evidence-based approaches that account for survival rates and colonisation dynamics.
Regulatory compliance gaps also derail clinical programmes. Products may lack the robust mode-of-action data required by agencies such as the FDA and EFSA for health-claim substantiation, leading to trial designs that cannot meet regulatory standards for demonstrating efficacy.
How can better preclinical testing predict probiotic clinical success?
Advanced preclinical methodologies using ex vivo gut simulation technologies can bridge the gap between laboratory research and clinical outcomes by providing validated, predictive insights into probiotic mechanisms of action. These approaches address the fundamental limitations of traditional testing methods.
Validated microbiome models must demonstrate three core criteria: reproducibility through standardised protocols, predictive validity proven by correlation with clinical outcomes, and proper standardisation, including negative controls. The strongest evidence comes from published validation studies showing a direct correlation between preclinical results and human clinical trial outcomes.
Ex vivo technologies can generate insights within 1–2 days that mirror clinical outcomes that would otherwise require weeks of repeated probiotic intake. This rapid turnaround enables comprehensive screening of multiple formulations, doses, and target populations before committing to expensive clinical trials.
Effective preclinical testing must preserve the original microbial composition from sample collection through fermentation, maintaining individual donor characteristics and physiologically relevant conditions, including appropriate pH levels, oxygen conditions, and nutrient availability. This biological relevance ensures that preclinical findings translate meaningfully to human responses.
Why do probiotics work differently across different populations?
Probiotics demonstrate variable efficacy across populations because each person’s gut microbiome is as unique as a fingerprint, creating interpersonal differences that drive variable responses to interventions. This variability significantly contributes to clinical trial failure rates when products fail to show consistent effects across diverse populations.
Baseline microbiome composition varies dramatically between individuals based on genetics, diet, age, geography, and health status. These differences affect probiotic survival, colonisation potential, and metabolic interactions with existing gut bacteria. For example, individuals with different enterotypes may respond very differently to the same probiotic strain.
Age-related changes create additional complexity. Infant, adult, and elderly microbiomes have distinct compositions and functional capacities that influence probiotic efficacy. Disease states further modify gut environments, as seen in conditions such as inflammatory bowel disease, where dysbiotic microbiomes may respond differently to probiotic interventions.
Dietary influences compound these variations. Individuals consuming different macronutrient profiles, fibre types, or cultural diets provide varying substrates and environmental conditions that affect probiotic performance. Understanding responder versus non-responder profiles before clinical trials is crucial for developing personalised nutrition strategies and improving trial success rates.
What role does regulatory compliance play in probiotic trial failures?
Regulatory compliance failures represent a major cause of probiotic clinical trial disappointments, as agencies such as the FDA and EFSA demand robust mode-of-action data and comprehensive safety documentation that many products lack. Common compliance pitfalls include insufficient mechanistic evidence, inadequate safety data, and poor study design.
Documentation standards require detailed characterisation of probiotic strains, including genetic identification, stability data, and manufacturing specifications. Many products enter trials without meeting these basic requirements, leading to regulatory rejection or trial suspension.
Health-claim substantiation demands evidence linking specific probiotic effects to measurable health outcomes through validated biomarkers. Products lacking this mechanistic foundation cannot support the health claims necessary for market success, regardless of clinical trial results.
Safety data requirements extend beyond basic toxicology to include interaction studies, contraindication identification, and adverse-event monitoring protocols. Inadequate safety documentation can halt trials or limit market access even when efficacy is demonstrated.
Regulatory acceptance increasingly favours human-relevant preclinical data over animal studies, particularly given legislative movements such as the FDA Modernization Act 2.0, which promotes non-animal approaches. Products relying solely on animal data may face regulatory challenges that could have been avoided with appropriate preclinical validation.
How Cryptobiotix helps prevent probiotic clinical trial failures
Cryptobiotix addresses probiotic clinical trial failure risks through our validated SIFR® technology platform, which provides predictive ex vivo gut simulation that bridges the gap between preclinical research and clinical outcomes. Our approach directly tackles the primary failure modes that derail probiotic development programmes.
Our comprehensive preclinical validation services include:
- Mechanistic evidence generation for patent protection and regulatory dossiers through multi-omics analysis
- Population-specific modelling using microbiomes from diverse cohorts, including infants, adults, the elderly, and disease states
- Responder/non-responder identification through high-throughput testing with a minimum of 6–8 donors per cohort
- Dose-response optimisation and formulation screening before committing to clinical trials
- Tolerability assessment through gas production measurement and safety biomarkers
The SIFR® technology generates validated insights within days that predict clinical outcomes that typically require weeks of testing, enabling rapid de-risking of product development. Our scientific publications demonstrate a direct correlation between SIFR® results and clinical trial outcomes across multiple applications in functional foods, pharmaceuticals, and biotechnology.
Ready to de-risk your probiotic development programme? Contact our team to discuss how SIFR® technology can provide the predictive insights needed for clinical success.
Frequently Asked Questions
How long should I wait before conducting clinical trials after preclinical validation?
With validated ex vivo gut simulation technologies like SIFR®, you can obtain predictive insights within 1-2 days that correlate with clinical outcomes. However, allow 2-4 weeks for comprehensive preclinical validation including dose-response optimization, population-specific testing, and regulatory documentation preparation before initiating clinical trials.
What's the minimum number of donor samples needed for reliable preclinical testing?
For statistically meaningful results, use a minimum of 6-8 donors per target cohort (e.g., healthy adults, elderly, disease states). This sample size helps identify responder/non-responder patterns and accounts for inter-individual microbiome variability that could impact clinical trial outcomes.
Can I use animal study data to support my probiotic's regulatory submission?
While animal data may still be accepted, regulatory agencies increasingly favor human-relevant preclinical data, especially following the FDA Modernization Act 2.0. Ex vivo human gut simulation provides more predictive and regulatory-acceptable evidence than animal models for probiotic applications.
What should I do if my probiotic shows inconsistent effects across different populations?
Inconsistent population responses suggest the need for personalized approaches. Conduct population-specific preclinical testing to identify responder profiles, then design stratified clinical trials targeting specific demographics or microbiome types rather than pursuing broad-population claims.
How do I determine the optimal dosage for my probiotic before clinical trials?
Avoid arbitrary dosing by conducting systematic dose-response studies using validated preclinical models. Test multiple concentrations while measuring survival rates, colonization dynamics, and functional outcomes. This evidence-based approach prevents dosage-related clinical trial failures and supports regulatory submissions.